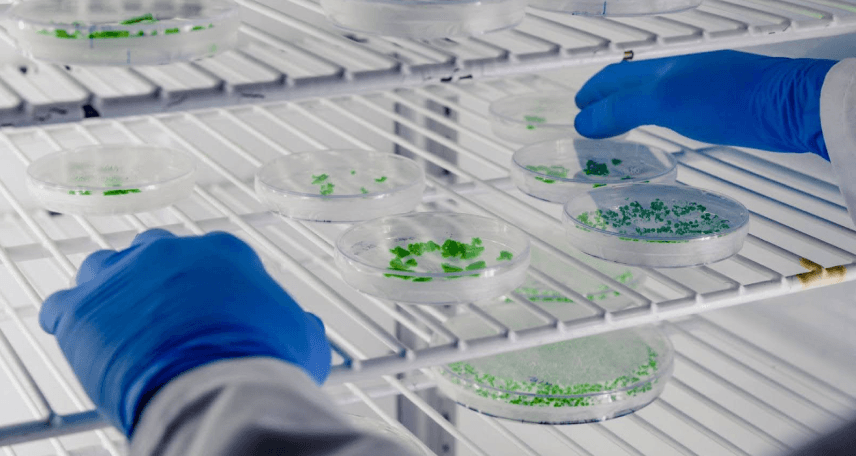
HACCP for Microbiologists: Step-by-Step Guide from Hazards to Critical Control Points

by Mrudula Kulkarni
10 minutes
HACCP for Microbiologists: Step-by-Step Guide from Hazards to Critical Control Points
Explore how microbiologists ensure HACCP compliance through predictive microbial control and safety innovation.
If you’ve ever found yourself juggling petri dishes, data sheets, and corrective actions, wondering how all this connects to food or pharma safety, you’re not alone. Microbiologists are the unseen guardians behind Hazard Analysis and Critical Control Points — or HACCP — systems that keep products, processes, and ultimately, people safe.
Integrating insights from nonviable particle monitoring in controlled environments strengthens environmental control and links HACCP data with contamination prevention.
But HACCP isn’t just a compliance framework; it’s a mindset — one that transforms reactive quality checks into proactive microbial control. Let’s break it down, from hazards to critical control points (CCPs), and see how microbiologists can make this system truly work.
What Is HACCP, Really?
HACCP (Hazard Analysis and Critical Control Points) is a systematic, science-based approach to identifying, evaluating, and controlling hazards that threaten product safety. Real-world Grade A/B cleanroom excursion investigations highlight how structured risk analysis complements microbiological hazard assessments in HACCP programs.
Originally designed for NASA’s space food program, it’s now a gold standard across industries — especially in food, pharma, and biotech manufacturing.
For microbiologists, HACCP means taking ownership of how microorganisms behave in your environment, ingredients, and processes — then building a barrier system that ensures they never reach the end user.
As one microbiology QA lead puts it,
“HACCP is less about paperwork and more about predicting microbial behavior. When you think like a microbe, you prevent like a pro.”
The Microbiologist’s Role in HACCP
In most facilities, microbiologists are the bridge between science and safety. By integrating surface monitoring in pharmaceutical cleanrooms data, microbiologists can align hygiene trends directly with HACCP control verification.
Your role is not just to run tests, but to interpret what those results mean in real time. You’re the one who understands microbial load trends, growth kinetics, and environmental monitoring results — all vital in setting up effective control points.
Your daily actions influence:
- How hazards are identified and categorized
- Where CCPs are defined
- How limits are set
- What verification data looks like
In short, HACCP depends on microbiological insight to stay relevant and robust.
Step 1: Understanding Microbiological Hazards
A hazard, in HACCP terms, is any biological, chemical, or physical agent that could cause harm if not controlled. Microbiological hazards are often the hardest to predict because they’re invisible, fast-evolving, and thrive in the tiniest lapses of hygiene or temperature control.
Common biological hazards microbiologists must monitor include:
- Pathogenic bacteria (e.g., Salmonella, E. coli, Listeria monocytogenes)
- Spoilage organisms (Bacillus, Pseudomonas, yeasts, and molds)
- Toxin-producing microbes (Clostridium botulinum)
- Viruses and parasites (in specific food and biotech contexts)
In pharmaceutical manufacturing, the focus shifts to bioburden, endotoxins, and spore-forming bacteria, particularly in aseptic and sterile operations. Applying closed-system aseptic processing principles reduces open manipulations, strengthening microbial control within HACCP-based contamination frameworks.
Step 2: Mapping Hazards to CCPs (Critical Control Points)
Here’s where your microbiological expertise shines. A CCP is any step in the process where control can be applied to prevent or eliminate a hazard, or reduce it to an acceptable level.
For example:
Each CCP must be scientifically justified — and that’s where you come in. Your validation data, environmental monitoring results, and risk assessments provide the foundation for these justifications. Legacy facilities can implement a brownfield CCS modernization approach to bring HACCP-aligned microbial controls up to modern aseptic standards.
Step 3: Setting Critical Limits — and Knowing When to Act
Critical limits define the maximum or minimum values that ensure control at each CCP. For microbiologists, this could mean:
- Microbial load ≤ specified CFU/ml or CFU/g
- Sterility test = No growth
- Endotoxin ≤ specified EU/ml
- Temperature/time combo validated for microbial kill
These are not arbitrary — they’re backed by data. Your environmental monitoring, challenge studies, and trend analysis help justify why those numbers make sense.
Remember: If you can’t measure it, you can’t control it.
Step 4: Verification and Validation — The Microbiologist’s Backbone
Verification ensures your HACCP plan is working. Validation ensures it can work under defined conditions. Together, they keep the system honest.
Microbiologists play a key role in:
- Designing environmental monitoring (EM) programs
- Conducting media fill trials (in pharma)
- Performing trend analysis of EM and product test data
- Auditing cleaning and disinfection effectiveness
“Validation without microbiologists is like doing a sterility test without media — you might get a result, but you’ll never trust it.”
Step 5: Documentation — From Lab Records to Decision-Making Tools
Microbiological data is more than just numbers. It’s evidence that drives decision-making. That’s why your records must be accurate, traceable, and insightful. Electronic systems for HACCP documentation can help visualize trends and trigger alerts before limits are breached.
Incorporating rapid microbiological method implementation enables faster validation cycles and supports data-driven HACCP decision-making.
Make your reports readable for non-scientists — decision-makers depend on your interpretation.
Common HACCP Mistakes Microbiologists Can Avoid
Here’s a quick checklist to stay audit-ready and effective:
✅ Skipping hazard analysis because of “historical data” — every process change demands re-evaluation.
✅ Setting CCPs too broadly — focus on true points of control, not general steps.
✅ Ignoring environmental data trends — small spikes can signal emerging hazards.
✅ Treating validation as a one-time event — continuous verification is key.
✅ Poor communication between QA, production, and microbiology teams.
✅ Relying solely on test results — prevention > detection.
Digital Tools & AI in Modern HACCP
Today, microbiologists are stepping into a new era where AI-driven systems analyze environmental data, predict contamination risks, and even recommend corrective actions. HACCP is evolving into a predictive safety model.
Advanced tools integrate:
- Automated microbial counters
- Digital sensors for CCP monitoring
- AI-based trend analytics for EM data
- Cloud-based HACCP dashboards
By combining human expertise with digital intelligence, microbiologists can move from reactive testing to predictive prevention.
Final Thoughts
HACCP is not just a regulatory checkbox — it’s a living system powered by microbiological insight. You, as a microbiologist, are not just a participant but a gatekeeper of process integrity.
Whether you work in food, biotech, or pharma, your ability to interpret microbial behavior and translate it into actionable safety measures defines the strength of your HACCP plan.
So the next time you walk into the lab, think beyond petri dishes. You’re not just monitoring microbes — you’re safeguarding trust, one critical control point at a time.
FAQs
1. What is the main role of a microbiologist in HACCP?
Microbiologists identify and evaluate biological hazards, help define CCPs, and interpret data to ensure process control and product safety.
2. How do you validate a microbiological CCP?
Through controlled studies, environmental monitoring, and process simulations that demonstrate consistent microbial reduction or elimination.
3. What are common microbial hazards in pharma HACCP?
Bacillus, Pseudomonas, molds, and endotoxin-producing bacteria are key concerns, especially in sterile manufacturing.
4. How often should HACCP plans be reviewed?
At least annually, or whenever there are process, product, or facility changes.
5. Can AI improve HACCP implementation?
Yes — AI can analyze EM data, predict risks, and enhance traceability, making HACCP systems more proactive and data-driven.




